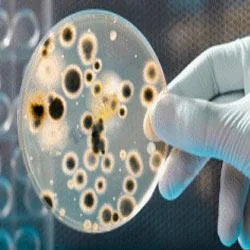
product-image-1

𝗪𝗵𝗮𝘁 𝗮𝗿𝗲 𝗣𝗮𝗽𝗲𝗿 & 𝗣𝘂𝗹𝗽 𝗠𝗮𝘁𝗲𝗿𝗶𝗮𝗹𝘀?
Paper and pulp materials are essential products derived from the processing of wood fibers. The pulp is created by breaking down wood into cellulose fibers, which are then processed into various types of paper products. These materials are fundamental in producing a wide range of items, including packaging, stationery, and hygiene products. The process involves chemical, mechanical, or semi-mechanical methods, each yielding different qualities and types of pulp.
The primary uses of paper and pulp materials span numerous industries, including packaging, printing, and construction. Businesses utilize these materials for creating everything from cardboard boxes to high-quality printing paper. In the packaging sector, paper and pulp materials are highly valued for their lightweight properties and recyclability. In addition, they play a crucial role in the hygiene industry, where they are used in products like tissues and paper towels. As the demand for sustainable and eco-friendly products rises, the relevance of paper and pulp materials continues to grow, with a robust market that adapts to consumer preferences.
𝗞𝗲𝘆 𝗙𝗲𝗮𝘁𝘂𝗿𝗲𝘀 𝗮𝗻𝗱 𝗦𝗽𝗲𝗰𝗶𝗳𝗶𝗰𝗮𝘁𝗶𝗼𝗻𝘀
Paper and pulp materials come with a variety of features and specifications that cater to different industrial applications. Understanding these specifications is essential for businesses looking to source the right materials.
Key specifications include:
1. Fiber Composition
- This refers to the types of fibers used, including hardwood or softwood.
- Varies depending on the desired strength and texture of the final product.
2. Basis Weight
- Indicates the weight of the paper per unit area, typically measured in grams per square meter (gsm).
- Common ranges include 60-400 gsm for various paper products.
3. Brightness
- Measures the reflectivity of the paper, affecting its visual appeal.
- Brightness levels can range from low (30-70) to high (80-100).
4. Opacity
- Describes how much light passes through the paper.
- Higher opacity is essential for printing applications to prevent show-through.
5. Whiteness
- Refers to the paper's overall color quality and purity.
- Measured on a scale, with higher values indicating whiter paper.
6. Moisture Content
- Critical for maintaining the integrity of paper products.
- Typically ranges from 4% to 10%, depending on the application.
7. Tear Resistance
- Indicates the paper's ability to withstand tearing forces.
- Measured in grams or Newtons.
8. Environmental Compliance
- Specifies adherence to eco-friendly standards and certifications.
- Important for businesses focusing on sustainability practices.
In summary, understanding these specifications helps businesses choose the right paper and pulp materials for their specific needs.
𝗖𝗼𝗺𝗺𝗼𝗻 𝗔𝗽𝗽𝗹𝗶𝗰𝗮𝘁𝗶𝗼𝗻𝘀 𝗮𝗻𝗱 𝗨𝘀𝗲 𝗖𝗮𝘀𝗲𝘀
Paper and pulp materials are versatile and serve various industries effectively.
1. Packaging Industry: These materials are widely used for creating cardboard boxes and other packaging solutions that ensure product safety during transport.
2. Printing Industry: High-quality paper is essential for printing books, magazines, and marketing materials, providing the necessary surface for vibrant colors and sharp images.
3. Hygiene Products: The hygiene sector relies on paper and pulp materials for products like toilet paper, tissues, and paper towels, focusing on softness and absorbency.
4. Construction Industry: Paper-based materials are utilized in various construction applications, including insulation and wall coverings, valued for their lightweight and thermal properties.
5. Stationery Products: Notebooks, writing pads, and other stationery items are produced from paper and pulp materials, emphasizing aesthetics and usability.
6. Arts and Crafts: Pulp materials are also used in creating art supplies, including sketchbooks and drawing paper, catering to artists’ needs.
7. Food Packaging: Biodegradable paper materials are increasingly used in food packaging to align with health and environmental standards.
𝗣𝗿𝗼𝗱𝘂𝗰𝘁 𝗩𝗮𝗿𝗶𝗮𝗻𝘁𝘀 𝗮𝗻𝗱 𝗦𝘂𝗯𝗰𝗮𝘁𝗲𝗴𝗼𝗿𝗶𝗲𝘀
Paper and pulp materials are available in various forms to meet diverse needs.
Recycled Paper
This variant is made from post-consumer waste, offering an eco-friendly alternative to traditional paper. It maintains quality while reducing environmental impact, making it ideal for businesses focused on sustainability.
Specialty Paper
Specialty paper includes products designed for specific uses, such as photographic paper or thermal paper. These papers often have unique features, such as enhanced durability or specific texture, catering to niche markets.
Coated Paper
Coated paper has a smooth finish that enhances print quality. It is commonly used for high-end printing applications where image clarity and color vibrancy are essential.
Newsprint
This low-cost paper is used primarily for printing newspapers. It is lightweight and designed for quick production, making it suitable for high-volume printing.
𝗕𝗲𝗻𝗲𝗳𝗶𝘁𝘀 𝗮𝗻𝗱 𝗔𝗱𝘃𝗮𝗻𝘁𝗮𝗴𝗲𝘀
Sourcing paper and pulp materials offers numerous benefits for businesses.
1. Sustainability: These materials are often sourced from renewable resources, providing a more sustainable option compared to synthetic alternatives.
2. Versatility: The wide range of applications makes paper and pulp materials suitable for various industries, increasing their utility.
3. Cost-effectiveness: Generally, paper and pulp materials are more affordable than many synthetic materials, offering economic advantages for businesses.
4. Customization: Many suppliers offer options for custom specifications, allowing businesses to tailor materials to their specific needs.
5. Recyclability: Paper and pulp products are easily recyclable, which aligns with environmental goals and reduces waste.
6. Availability: A robust supply chain ensures that businesses can source these materials readily, minimizing lead times and stock shortages.
𝗕𝘂𝘆𝗶𝗻𝗴 𝗚𝘂𝗶𝗱𝗲 𝗳𝗼𝗿 𝗕𝟮𝗕 𝗕𝘂𝘆𝗲𝗿𝘀
When sourcing paper and pulp materials, buyers should consider several critical factors.
1. Quality Assessment: Ensure that materials meet specific quality standards relevant to your application. Check for certifications and testing results that indicate reliability.
2. Supplier Verification: Vet suppliers thoroughly to ensure they have a history of reliable delivery and quality products. Look for reviews and industry reputation.
3. Pricing and MOQ: Consider the pricing structures and minimum order quantities (MOQ). Understanding these factors will help you manage your budget and inventory effectively.
4. Delivery and Lead Times: Discuss logistics with suppliers to confirm delivery times and understand how they align with your production schedules.
5. Compliance Requirements: Verify that materials meet all relevant regulatory and safety standards in your region, ensuring compliance with industry requirements.
𝗖𝗼𝗺𝗽𝗹𝗶𝗮𝗻𝗰𝗲 𝗮𝗻𝗱 𝗖𝗲𝗿𝘁𝗶𝗳𝗶𝗰𝗮𝘁𝗶𝗼𝗻𝘀
Paper and pulp materials must adhere to specific quality standards and certifications to ensure safety and performance. Relevant standards include ISO 9001, which pertains to quality management systems, and HACCP, which focuses on food safety.
Additionally, industry certifications such as UL and CE are crucial, particularly for products that will be used in sensitive applications. These certifications indicate that the materials have undergone rigorous testing and meet established safety and performance criteria.
Regional compliance is also a significant factor, as different regions may have varying regulations regarding environmental impact, safety, and usage. Ensuring that products meet these regional standards is essential for lawful and safe operations.
𝗪𝗵𝘆 𝗦𝗼𝘂𝗿𝗰𝗲 𝗣𝗮𝗽𝗲𝗿 & 𝗣𝘂𝗹𝗽 𝗠𝗮𝘁𝗲𝗿𝗶𝗮𝗹𝘀 𝗳𝗿𝗼𝗺 𝗣𝗲𝗽𝗮𝗴𝗼𝗿𝗮?
Pepagora is a trusted platform for sourcing paper and pulp materials, offering several key advantages to B2B buyers.
Verified Supplier Network: Pepagora connects buyers with a network of verified suppliers, ensuring that the sourcing process is both secure and efficient. This verification process helps in reducing risks associated with supplier reliability.
Streamlined RFQ Process: The platform features a streamlined Request for Quotation (RFQ) system, allowing buyers to quickly obtain quotes from multiple suppliers. This efficiency helps buyers compare prices and specifications easily.
Trade Assurance and Support: Pepagora provides trade assurance, offering buyer protection throughout the purchasing process. This support gives buyers confidence in their transactions, knowing they are safeguarded against disputes.
Regional Coverage: With a geographic reach that includes India, the GCC, and Southeast Asia, Pepagora effectively serves diverse markets. This regional coverage ensures that buyers can find local suppliers who understand their specific needs and regulations.